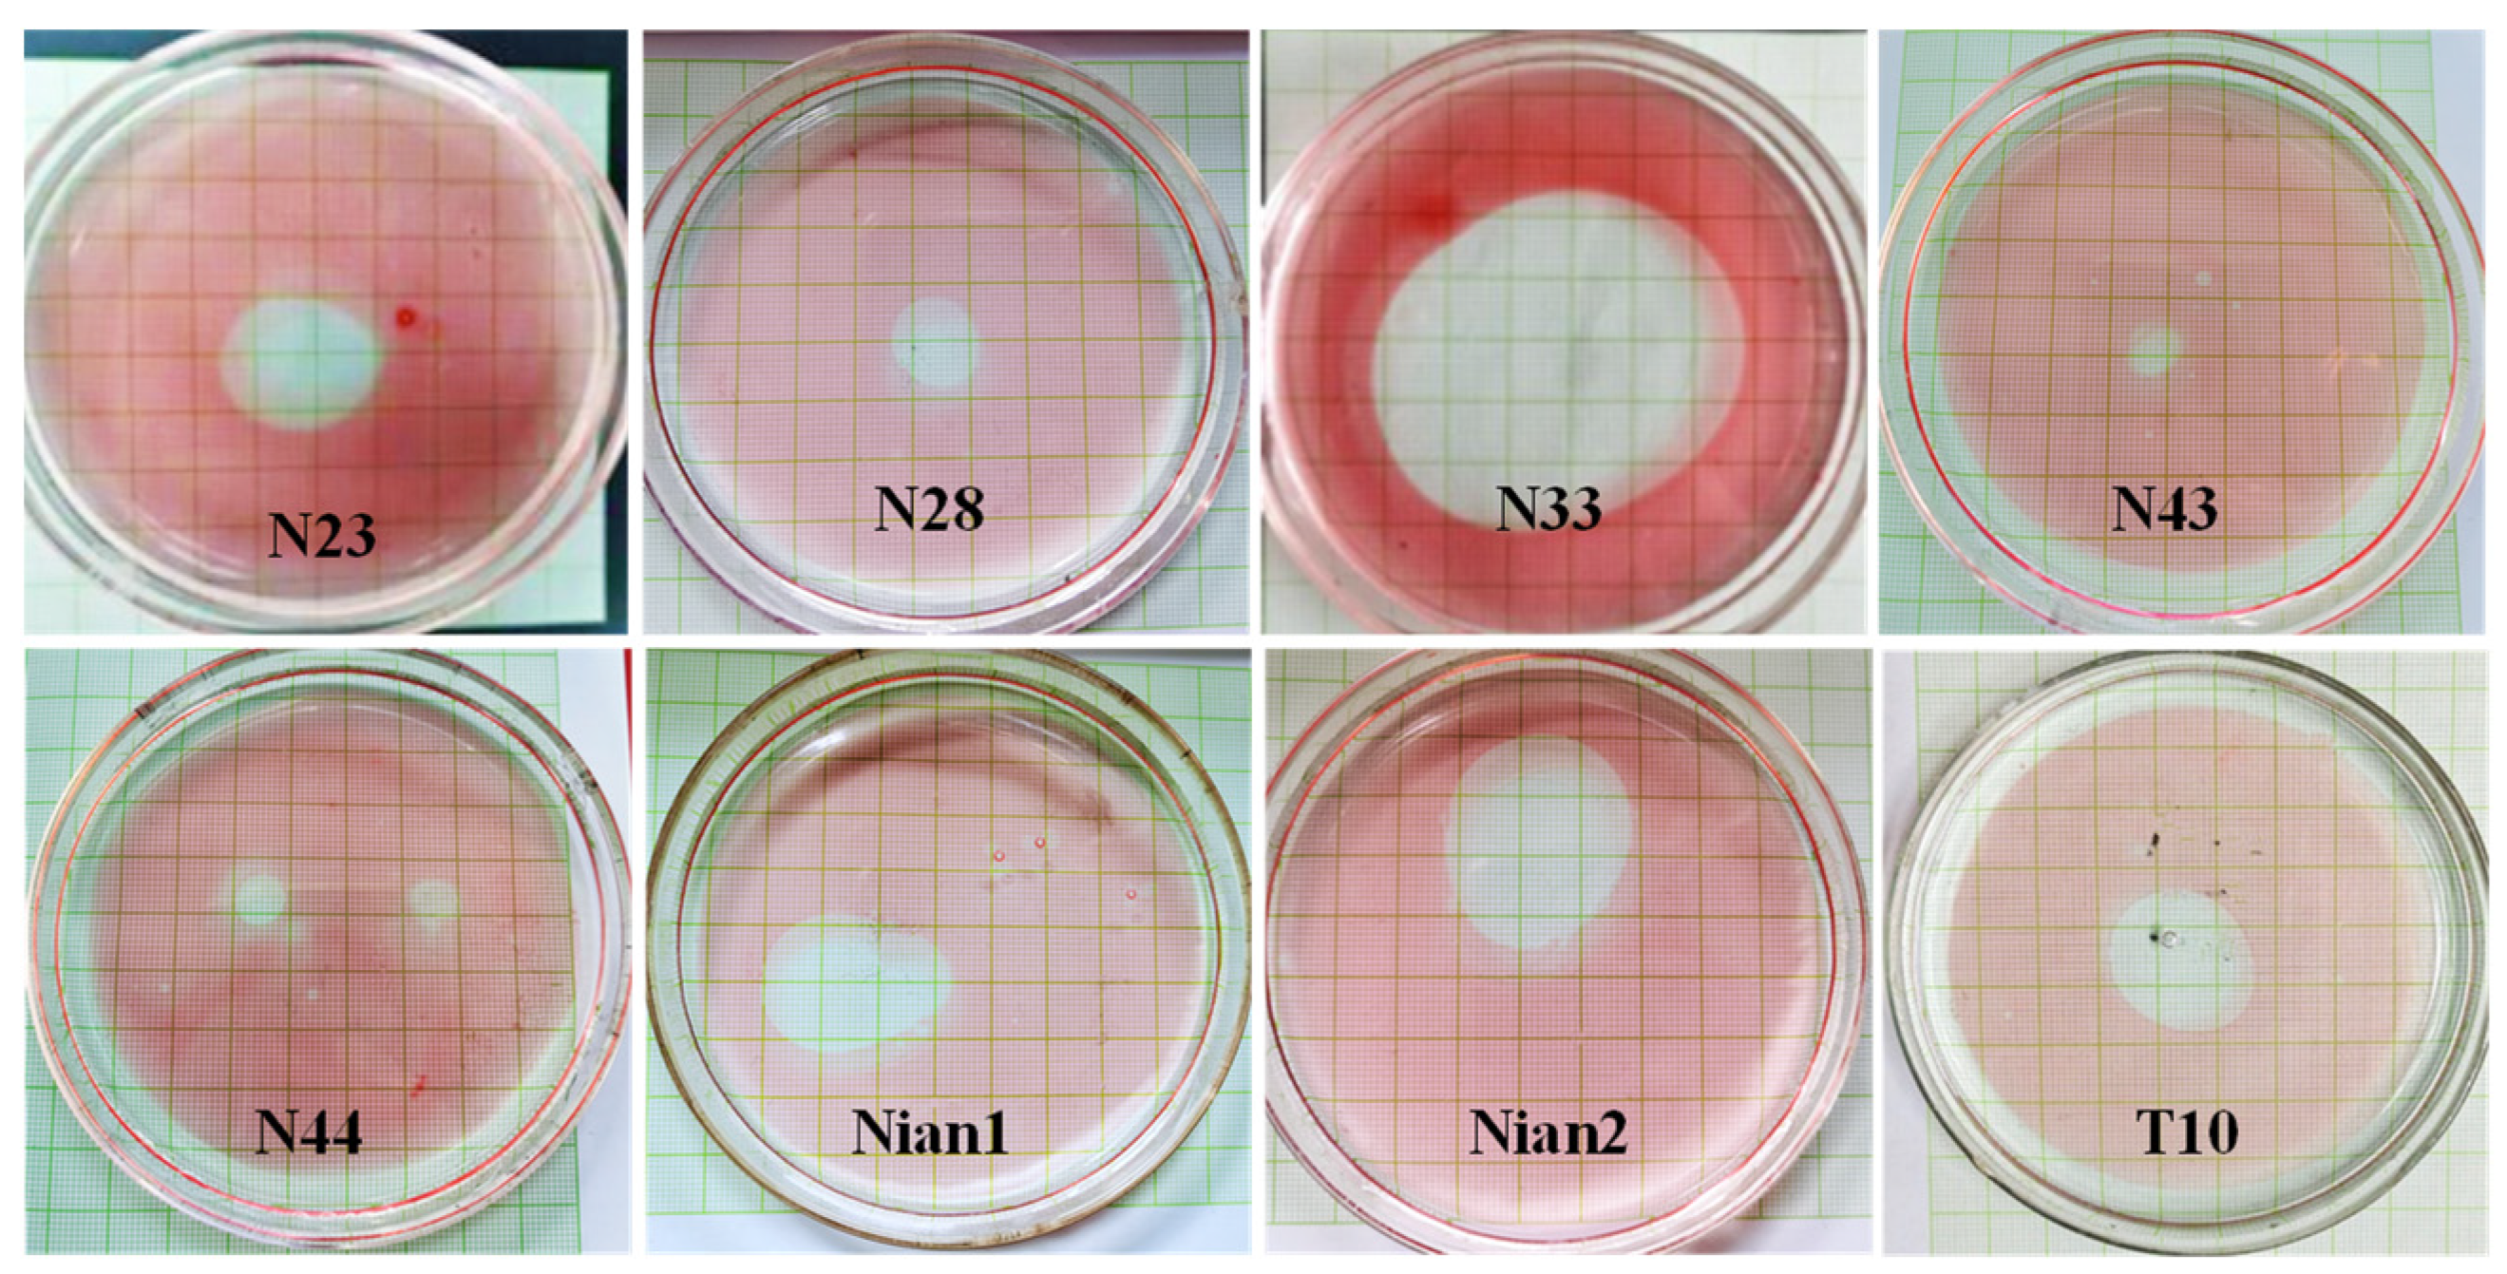

Isolation and Characterization of Biosurfactant-Producing Bacteria for Enhancing Oil Recovery
Abstract
1. Introduction
2. Materials and Methods
2.1. Isolation and Screening of Biosurfactant-Producing Bacteria
2.2. Identification of Surfactant-Producing Bacteria
2.3. Optimization of Biosurfactant Production Fermentation Conditions
2.4. Determination of Biosurfactant Stability
2.5. Emulsification Properties of Biosurfactants
2.6. Static Oil Washing Experiment
2.7. Oil Displacement Experiment
3. Results
3.1. Isolation, Screening, and Identification of Surfactant-Producing Bacteria
3.2. Optimization of Biosurfactant Production Fermentation Conditions
3.3. Stability Tests of Biosurfactants
3.4. Emulsification of Crude Oil by Biosurfactants
3.5. Static Oil-Washing Efficiency of Biosurfactants
3.6. Oil Displacement Efficiency of Biosurfactants
4. Discussion
4.1. Diversity of Biosurfactant-Producing Bacteria
4.2. Factors Affecting Bacterial Biosurfactant Production
4.3. Bacterial Surfactant Stability: Thermal and Ion Tolerance
4.4. Emulsification Properties of Bacterial Surfactants
4.5. Bacterial Surfactants and Their Environmental and EOR Applications
5. Conclusions
Author Contributions
Funding
Data Availability Statement
Conflicts of Interest
References
- Thomas, S. Enhanced oil recovery—An overview. Oil Gas Sci. Technol. 2008, 63, 9–19. [Google Scholar] [CrossRef]
- Nikolova, C.; Gutierrez, T. Use of microorganisms in the recovery of oil from recalcitrant oil reservoirs: Current state of knowledge, technological advances, and future perspectives. Front. Microbiol. 2020, 10, 2996. [Google Scholar] [CrossRef] [PubMed]
- Alvarado, V.; Manrique, E. Enhanced oil recovery: An update review. Energies 2010, 3, 1529–1575. [Google Scholar] [CrossRef]
- Kamal, M.S.; Hussein, I.A.; Sultan, A.S. Review on surfactant flooding: Phase behavior, retention, IFT, and field applications. Energy Fuels 2017, 31, 7701–7720. [Google Scholar] [CrossRef]
- Negin, C.; Ali, S.; Xie, Q. Application of nanotechnology for enhancing oil recovery—A review. Petroleum 2016, 2, 324–333. [Google Scholar] [CrossRef]
- Banat, I.M.; Makkar, R.S.; Cameotra, S.S. Potential commercial applications of microbial surfactants. Appl. Microbiol. Biotechnol. 2000, 53, 495–508. [Google Scholar] [CrossRef]
- Santos, D.; Rufino, R.; Luna, J.; Santos, V.A.; Sarubbo, L. Biosurfactants: Multifunctional biomolecules of the 21st century. Int. J. Mol. Sci. 2016, 17, 401. [Google Scholar] [CrossRef]
- Jiang, J.; Zu, Y.; Li, X.; Meng, Q.; Long, X. Recent progress towards industrial rhamnolipids fermentation: Process optimization and foam control. Bioresour. Technol. 2020, 298, 122394. [Google Scholar] [CrossRef]
- Marchant, R.; Banat, I.M. Microbial biosurfactants: Challenges and opportunities for future exploitation. Trends Biotechnol. 2012, 30, 558–565. [Google Scholar] [CrossRef]
- Liu, Q.; Myers, R.; Niu, J.; Gonçalves, T.; Rosa, Y.; Liu, Y.; Li, L.; Lv, J. Optimization of lipopeptide biosurfactant production by Bacillus licheniformis L20 and performance evaluation of biosurfactant mixed system for enhanced oil recovery. J. Pet. Sci. Eng. 2022, 208, 109678. [Google Scholar] [CrossRef]
- Alkan, S.; Sehitoglu, H. Investigation of spontaneous imbibition induced by wettability alteration as a recovery mechanism in microbial enhanced oil recovery. J. Pet. Sci. Eng. 2019, 175, 182–195. [Google Scholar] [CrossRef]
- Niu, J.; Liu, Q.; Lv, J.; Peng, B. Review on microbial enhanced oil recovery: Mechanisms, modeling, and field trials. J. Pet. Sci. Eng. 2020, 192, 107350. [Google Scholar] [CrossRef]
- Sen, R. Biotechnology in petroleum recovery: The microbial EOR. Prog. Energy Combust. Sci. 2008, 34, 714–724. [Google Scholar] [CrossRef]
- Al-Sulaimani, H.; Joshi, S.; Al-Wahaibi, Y.; Al-Bahry, S.; Elshafie, A.; Al-Bemani, A. Microbial biotechnology for enhancing oil recovery: Current developments and future prospects. Biotechnol. Bioinform. Bioeng. J. 2011, 1, 147–158. [Google Scholar]
- Ron, E.Z.; Rosenberg, E. Natural roles of biosurfactants. Environ. Microbiol. 2001, 3, 229–236. [Google Scholar] [CrossRef] [PubMed]
- Hommel, R.K.; Stiiwer, O.; Stuber, W.; Haferburg, D.; Kleber, H.P. Production of water-soluble surface-active exolipids by Torulopsis apicola. Appl. Microbiol. Biotechnol. 1987, 26, 199–205. [Google Scholar] [CrossRef]
- Hassanshahian, M.; Emtiazi, G.; Cappello, S. Isolation and characterization of crude-oil-degrading bacteria from the Persian Gulf and the Caspian Sea. Mar. Pollut. Bull. 2012, 64, 7–12. [Google Scholar] [CrossRef]
- Wang, W.; Cai, B.; Shao, Z. Oil degradation and biosurfactant production by the deep sea bacterium Dietzia maris As-13-3. Front. Microbiol. 2014, 5, 119073. [Google Scholar] [CrossRef]
- Kügler, J.H.; Le Roes-Hill, M.; Syldatk, C.; Hausmann, R. Surfactants tailored by the class Actinobacteria. Front. Microbiol. 2015, 6, 212. [Google Scholar]
- Koretska, N.; Karpenko, O.; Baranov, V.; Lubenets, V.; Nogina, T. Biological properties of surface-active metabolites of Rhodococcus erythropolis Au-1 and their prospects for crop technology. Innov. Biosyst. Bioeng. 2019, 3, 77–85. [Google Scholar] [CrossRef]
- Khademolhosseini, R.; Jafari, A.; Mousavi, S.; Hajfarajollah, H.; Noghabi, K.; Manteghian, M. Physicochemical characterization and optimization of glycolipid biosurfactant production by a native strain of Pseudomonas aeruginosa HAK01 and its performance evaluation for the MEOR process. RSC Adv. 2019, 9, 7932–7947. [Google Scholar] [CrossRef] [PubMed]
- Morikawa, M.; Daido, H.; Takao, T.; Murata, S.; Shimonishi, Y.; Imanaka, T. A new lipopeptide biosurfactant produced by Arthrobacter sp. strain MIS38. J. Bacteriol. 1993, 175, 6459–6466. [Google Scholar] [CrossRef] [PubMed]
- Elazzazy, A.M.; Abdelmoneim, T.S.; Almaghrabi, O.A. Isolation and characterization of biosurfactant production under extreme environmental conditions by alkali-halo-thermophilic bacteria from Saudi Arabia. Saudi J. Biol. Sci. 2015, 22, 466–475. [Google Scholar] [CrossRef] [PubMed]
- Sarwar, A.; Brader, G.; Corretto, E.; Aleti, G.; Abaid-Ullah, M.; Sessitsch, A.; Hafeez, F.Y. Qualitative analysis of biosurfactants from Bacillus species exhibiting antifungal activity. PLoS ONE 2018, 13, e0198107. [Google Scholar]
- Jiao, R.; Cai, Y.; He, P.; Munir, S.; Li, X.; Wu, Y.; Wang, J.; Xia, M.; He, P.; Wang, G.; et al. Bacillus amyloliquefaciens YN201732 produces lipopeptides with promising biocontrol activity against fungal pathogen Erysiphe cichoracearum. Front. Cell. Infect. Microbiol. 2021, 9, 598999. [Google Scholar] [CrossRef]
- Liu, Q.; Niu, J.; Yu, Y.; Wang, C.; Lu, S.; Zhang, S.; Lv, J.; Peng, B. Production, characterization, and application of biosurfactant produced by Bacillus licheniformis L20 for microbial enhanced oil recovery. J. Clean. Prod. 2021, 307, 127193. [Google Scholar] [CrossRef]
- Zhao, F.; Zhu, H.; Cui, Q.; Wang, B.; Su, H.; Zhang, Y. Anaerobic production of surfactin by a new Bacillus subtilis isolate and the in situ emulsification and viscosity reduction effect towards enhanced oil recovery applications. J. Pet. Sci. Eng. 2021, 201, 108508. [Google Scholar] [CrossRef]
- Beebe, J.L.; Umbreit, W.W. Extracellular lipid of Thiobacillus thiooxidans. J. Bacteriol. 1971, 108, 612–614. [Google Scholar] [CrossRef]
- Akit, J.; Cooper, D.J.; Mannien, K.I.; Zajic, J.K. Investigation of potential biosurfactant production among phytopathogenic corynebacteria and related soil microbes. Curr. Microbiol. 1981, 6, 145–150. [Google Scholar] [CrossRef]
- Luo, P.; Tang, Y.; Lu, J.; Jiang, L.; Huang, Y.; Jiang, Q.; Chen, X.; Qin, T.; Shiels, H.A. Diesel degradation capability and environmental robustness of strain Pseudomonas aeruginosa WS02. J. Environ. Manag. 2023, 351, 119937. [Google Scholar] [CrossRef]
- Gaur, S.; Gupta, S.; Jha, P.N.; Jain, A. Rhamnolipid production by Pseudomonas aeruginosa (SSL-4) on waste engine oil (WEO): Taguchi optimization, soil remediation, and phytotoxicity investigation. Environ. Technol. 2023, 45, 4536–4549. [Google Scholar] [CrossRef] [PubMed]
- Geetha, S.J.; Banat, I.M.; Joshi, S.J. Biosurfactants: Production and potential applications in microbial enhanced oil recovery (MEOR). Biocatal. Agric. Biotechnol. 2018, 14, 23–32. [Google Scholar]
- Wu, B.; Wang, J.; Shi, S.; Zhang, Y.; Nie, Z.; Li, Y. Scale modelling, prediction, and management strategy in high-temperature high-salinity reservoir in the Middle East. In Proceedings of the ASME 2023 42nd International Conference on Ocean, Offshore and Arctic Engineering, Melbourne, Australia, 11–16 June 2023. [Google Scholar]
- Hadia, N.J.; Ng, Y.H.; Stubbs, L.P.; Torsæter, O. High salinity and high temperature stable colloidal silica nanoparticles with wettability alteration ability for EOR applications. Nanomaterials 2021, 11, 707. [Google Scholar] [CrossRef] [PubMed]
- Hassanshahian, M. Isolation and characterization of biosurfactant-producing bacteria from Persian Gulf (Bushehr provenance). Mar. Pollut. Bull. 2014, 86, 361–366. [Google Scholar] [CrossRef] [PubMed]
- Wei, S.; Cui, H.; Jiang, Z.; Liu, H.; He, H.; Fang, N. Biomineralization processes of calcite induced by bacteria isolated from marine sediments. Braz. J. Microbiol. 2015, 46, 455–464. [Google Scholar] [CrossRef]
- Parthipan, P.; Preetham, E.; Machuca, L.L.; Rahman, P.K.; Murugan, K.; Rajasekar, A. Biosurfactant and degradative enzymes mediated crude oil degradation by bacterium Bacillus subtilis A1. Front. Microbiol. 2017, 8, 237675. [Google Scholar] [CrossRef]
- Phulpoto, I.A.; Yu, Z.; Hu, B.; Wang, Y.; Ndayisenga, F.; Li, J.; Liang, H.; Qazi, M.A. Production and characterization of surfactin-like biosurfactant produced by novel strain Bacillus nealsonii S2MT and its potential for oil-contaminated soil remediation. Microb. Cell Fact. 2020, 19, 145. [Google Scholar] [CrossRef]
- Santa Anna, L.M.; Sebastian, G.V.; Menezes, E.P.; Alves, T.L.M.; Santos, A.S.; Pereira, N., Jr.; Freire, D.M.G. Production of biosurfactants from Pseudomonas aeruginosa PA 1 isolated in oil environments. Braz. J. Chem. Eng. 2002, 19, 159–166. [Google Scholar] [CrossRef]
- Amani, H.; Haghighi, M.; Keshtkar, M.J. Production and optimization of microbial surfactin by Bacillus subtilis for ex situ enhanced oil recovery. Pet. Sci. Technol. 2013, 31, 1249–1258. [Google Scholar] [CrossRef]
- Datta, P.; Tiwari, P.; Pandey, L.M. Oil washing proficiency of biosurfactant produced by isolated Bacillus tequilensis MK 729017 from Assam reservoir soil. J. Pet. Sci. Eng. 2020, 195, 107612. [Google Scholar] [CrossRef]
- Joshi, S.J.; Suthar, H.; Yadav, A.K.; Hingurao, K.; Nerurkar, A. Occurrence of biosurfactant-producing Bacillus spp. in diverse habitats. ISRN Biotechnol. 2012, 2013, 652340. [Google Scholar] [CrossRef] [PubMed]
- Kaya, T.; Aslim, B.; Kariptaş, E. Production of biosurfactant by Pseudomonas spp. isolated from industrial waste in Turkey. Turk. J. Biol. 2014, 38, 307–317. [Google Scholar] [CrossRef]
- Zhu, Z.; Zhang, B.; Chen, B.; Cai, Q.; Lin, W. Biosurfactant production by marine-originated bacteria Bacillus subtilis and its application for crude oil removal. Water Air Soil Pollut. 2016, 227, 328. [Google Scholar] [CrossRef]
- Talukdar, P.; Sharma, C.; Doley, A.; Baruah, K.; Borah, A.; Agarwal, P.; Deori, P. Isolation and characterization of biosurfactant-producing microorganisms from petroleum-contaminated soil samples for EOR and bioremediation. Pet. Sci. Technol. 2017, 35, 2102–2108. [Google Scholar] [CrossRef]
- Uyar, E.; Sağlam, Ö. Isolation, screening, and molecular characterization of biosurfactant-producing bacteria from soil samples of auto repair shops. Arch. Microbiol. 2021, 203, 4929–4939. [Google Scholar] [CrossRef]
- Ivanova, A.E.; Sokolova, D.S.; Kanat’eva, A.Y. Hydrocarbon biodegradation and surfactant production by acidophilic mycobacteria. Microbiology 2016, 85, 317–324. [Google Scholar] [CrossRef]
- Portal, A.; Lima de Albuquerque, T.; Maciel Melo, V.M.; Silveira Vieira, R.; Ponte Rocha, M.V. Biosurfactant production by Acinetobacter venetianus and its application in bioremediation. Chem. Eng. Technol. 2023, 46, 1106–1114. [Google Scholar] [CrossRef]
- Sanmartin Negrete, P.; Ghilardi, C.; Rodriguez Pineda, L.; Pérez, E.; Herrera, M.L.; Borroni, V. Biosurfactant production by Rhodococcus ALDO1 isolated from olive mill wastes. Biocatal. Agric. Biotechnol. 2024, 57, 103106. [Google Scholar] [CrossRef]
- Nikolova, C.; Gutierrez, T. Biosurfactants and their applications in the oil and gas industry: Current state of knowledge and future perspectives. Front. Bioeng. Biotechnol. 2021, 9, 626639. [Google Scholar] [CrossRef]
- Domingues, P.M. Isolation of Estuarine Biosurfactant-Producing Bacteria. Master’s Thesis, Universidade de Aveiro, Aveiro, Portugal, 2011. [Google Scholar]
- Hadiya, P.; Ansari, R. The multifaceted role of microbial biosurfactants in various fields. Int. J. Multidiscip. Res. 2024, 6, 17112. [Google Scholar]
- Singh, S.; Sachan, A. Evaluation of nutritional and environmental factors for biosurfactant production by soil bacteria. Res. Sq. 2024; preprint. [Google Scholar] [CrossRef]
- Bezza, F.; Chirwa, E. Improvement of biosurfactant production by microbial strains through supplementation of hydrophobic substrates. Chem. Eng. Trans. 2020, 79, 91–96. [Google Scholar]
- Deepika, K.V.; Kalam, S.; Sridhar, P.R.; Podile, A.R.; Bramhachari, P.V. Optimization of rhamnolipid biosurfactant production by mangrove sediment bacterium Pseudomonas aeruginosa KVD-HR42 using response surface methodology. Biocatal. Agric. Biotechnol. 2016, 5, 38–47. [Google Scholar] [CrossRef]
- Ezebuiro, V.; Otaraku, I.; Oruwari, B.; Okpokwasili, G. Effects of nitrogen and carbon sources on biosurfactant production by hydrocarbon-utilizing Stenotrophomonas sp. Microbiol. Res. J. Int. 2019, 29, 1–10. [Google Scholar] [CrossRef]
- Purwasena, I.A.; Amaniyah, M.; Astuti, D.I.; Firmansyah, Y.; Sugai, Y. Production, characterization, and application of Pseudoxanthomonas taiwanensis biosurfactant: A green chemical for microbial enhanced oil recovery (MEOR). Sci. Rep. 2024, 14, 10270. [Google Scholar] [CrossRef]
- Gurjar, J.; Sengupta, B. Production of surfactin from rice mill polishing residue by submerged fermentation using Bacillus subtilis MTCC 2423. Bioresour. Technol. 2015, 189, 243–249. [Google Scholar] [CrossRef]
- Ahmad, Z.; Zhang, X.; Imran, M.; Zhong, H.; Andleeb, S.; Zulekha, R.; Liu, G.; Ahmad, I.; Coulon, F. Production, functional stability, and effect of rhamnolipid biosurfactant from Klebsiella sp. on phenanthrene degradation in various medium systems. Ecotoxicol. Environ. Saf. 2021, 207, 111514. [Google Scholar] [CrossRef]
- Amani, H.; Sarrafzadeh, M.H.; Haghighi, M.; Mehrnia, M.R. Comparative study of biosurfactant-producing bacteria in MEOR applications. J. Pet. Sci. Eng. 2010, 75, 209–214. [Google Scholar] [CrossRef]
- Silva, S.N.R.L.; Farias, C.B.B.; Rufino, R.D.; Luna, J.M.; Sarubbo, L.A. Glycerol as substrate for the production of biosurfactant by Pseudomonas aeruginosa UCP0992. Colloids Surf. B Biointerfaces 2010, 79, 174–183. [Google Scholar] [CrossRef]
- Vaz, D.A.; Gudiña, E.J.; Jurado Alameda, E.; Teixeira, J.A.; Rodrigues, L.R. Performance of a biosurfactant produced by a Bacillus subtilis strain isolated from crude oil samples as compared to commercial chemical surfactants. Colloids Surf. B Biointerfaces 2012, 89, 167–174. [Google Scholar] [CrossRef]
- Gargouri, B.; Contreras, M.D.; Ammar, S.; Segura-Carretero, A.; Bouaziz, M. Biosurfactant production by the crude oil degrading Stenotrophomonas sp. B-2: Chemical characterization, biological activities, and environmental applications. Environ. Sci. Pollut. Res. 2017, 24, 3769–3779. [Google Scholar] [CrossRef] [PubMed]
- Gowthaman, S.; Krishnya, S.; Nasvi, M. Effect of salinity on mechanical behavior of well cement: Application to carbon capture and storage wells. Eng. J. Inst. Eng. Sri Lanka 2016, 49, 21. [Google Scholar]
- Haque, E.; Riyaz, M.; Shankar, S.; Hassan, S. Physiochemical and structural characterization of biosurfactant produced by halophilic Pseudomonas aeruginosa ENO14 isolated from seawater. Int. J. Pharm. Investig. 2020, 10, 437–444. [Google Scholar] [CrossRef]
- Câmara, J.; Sousa, M.; Barros Neto, E.; Oliveira, M. Application of rhamnolipid biosurfactant produced by Pseudomonas aeruginosa in microbial-enhanced oil recovery (MEOR). J. Pet. Explor. Prod. Technol. 2019, 9, 2333–2341. [Google Scholar] [CrossRef]
- Hu, X.; Subramanian, K.; Wang, H.; Roelants, S.L.K.W.; To, M.H.; Soetaert, W.; Kaur, G.; Lin, C.S.K.; Chopra, S.S. Guiding environmental sustainability of emerging bioconversion technology for waste-derived sophorolipid production by adopting a dynamic life cycle assessment (dLCA) approach. Environ. Pollut. 2021, 269, 116101. [Google Scholar] [CrossRef]
- Gogoi, D.; Bhagowati, P.; Gogoi, P.; Bordoloi, N.K.; Rafay, A.; Dolui, S.K.; Mukherjee, A.K. Structural and physico-chemical characterization of a dirhamnolipid biosurfactant purified from Pseudomonas aeruginosa: Application of crude biosurfactant in enhanced oil recovery. RSC Adv. 2016, 6, 70669–70681. [Google Scholar] [CrossRef]
- Raouf, S.; Ismail, Y.; Gamaleldin, N.; Aboelkhair, H.; Attia, A. Screening of sustainable biosurfactant produced by indigenous bacteria isolated from Egyptian oil fields for microbial enhanced oil recovery. Geoenergy Sci. Eng. 2024, 239, 212974. [Google Scholar] [CrossRef]
- Fulazzaky, M.; Astuti, D.; Fulazzaky, M.A. Laboratory simulation of microbial enhanced oil recovery using Geobacillus toebii R-32639 isolated from the Handil reservoir. RSC Adv. 2015, 5, 3908. [Google Scholar] [CrossRef]

Disclaimer/Publisher’s Note: The statements, opinions and data contained in all publications are solely those of the individual author(s) and contributor(s) and not of MDPI and/or the editor(s). MDPI and/or the editor(s) disclaim responsibility for any injury to people or property resulting from any ideas, methods, instructions or products referred to in the content. |
© 2024 by the authors. Licensee MDPI, Basel, Switzerland. This article is an open access article distributed under the terms and conditions of the Creative Commons Attribution (CC BY) license (https://creativecommons.org/licenses/by/4.0/).
Share and Cite
Jiang, M.; Wang, H.; Liu, J.; Hou, X.; Zhang, Y.; Liu, X.; Wei, S.; Cui, Q. Isolation and Characterization of Biosurfactant-Producing Bacteria for Enhancing Oil Recovery. Processes 2024, 12, 2575. https://doi.org/10.3390/pr12112575
Jiang M, Wang H, Liu J, Hou X, Zhang Y, Liu X, Wei S, Cui Q. Isolation and Characterization of Biosurfactant-Producing Bacteria for Enhancing Oil Recovery. Processes. 2024; 12(11):2575. https://doi.org/10.3390/pr12112575
Chicago/Turabian StyleJiang, Meiyu, Hongyi Wang, Jiahui Liu, Xuan Hou, Yuanyuan Zhang, Xiaolin Liu, Shiping Wei, and Qingfeng Cui. 2024. "Isolation and Characterization of Biosurfactant-Producing Bacteria for Enhancing Oil Recovery" Processes 12, no. 11: 2575. https://doi.org/10.3390/pr12112575
APA StyleJiang, M., Wang, H., Liu, J., Hou, X., Zhang, Y., Liu, X., Wei, S., & Cui, Q. (2024). Isolation and Characterization of Biosurfactant-Producing Bacteria for Enhancing Oil Recovery. Processes, 12(11), 2575. https://doi.org/10.3390/pr12112575

